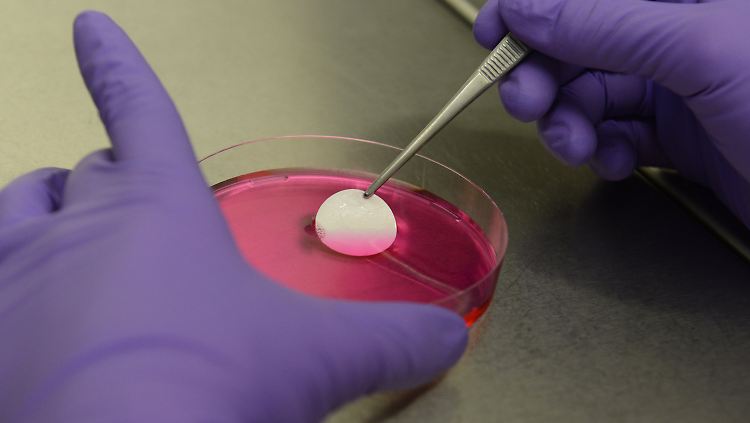

Eine ideale Lösung gibt es noch nicht Neuartige Herzklappen für Kinder gesucht
07.12.2013, 11:25 Uhr
Getestet wird an einer Herzklappe vom Schwein.
(Foto: dpa)
Babys mit angeborenem Herzfehler sind oft auf eine neue Herzklappe angewiesen. Das Problem: Die Anzahl biologischer Klappen ist gering, zudem ist die Abwehrreaktion des Körpers bei Kindern hoch. Forscher suchen nach Alternativen. Da gilt es einige Hürden zu nehmen.
Groß wie eine Ein-Euro-Münze, hauchdünn und weiß - laut Katja Schenke-Layland könnte so die ideale Lösung für ein Problem in der Kinderherzchirurgie aussehen. Denn alle bisher anwendbaren Methoden zum Ersatz von Herzklappen seien fehleranfällig, meint die Leiterin der Abteilung Zellsysteme am Stuttgarter Fraunhofer-Institut für Grenzflächen- und Bioverfahrenstechnik (IGB). Schweineklappen hätten schon zum Tod der Patienten geführt, andere Klappenmodelle wüchsen nicht ausreichend mit. Entweder werden somit viele Operationen nötig, oder man greift auf Spenderklappen gestorbener Menschen zurück, deren Zahl jedoch auch begrenzt ist.
Eine Möglichkeit: Herzklappen, die nach einem ähnlichen Prinzip wachsen wie Zuckerwatte.
(Foto: dpa)
"Es sind schon sehr erfolgreiche Maßnahmen in der Medizin entwickelt worden, die viele Leben gerettet haben. Aber keine davon ist komplikationslos", bestätigt Thomas Eschenhagen, Vorstandschef des Deutschen Zentrums für Herz-Kreislauf-Forschung (DZHK) in Berlin. "Gerade Kinder mit angeborenem Herzfehler brauchen schon sehr früh sehr kleine Klappen. Das ist eine Herausforderung."
Kinderherzchirurg Alexander Horke aus der Arbeitsgruppe von Prof. Axel Haverich an Medizinischen Hochschule Hannover sagt: "Mechanische Spenderklappen brauchen eine lebenslange Blutverdünnung, menschliche oder tierische Spenderklappen erkennt der Mensch mehr oder weniger heftig als fremd. Dadurch wird eine Abwehrreaktion in Gang gesetzt, die zum Funktionsverlust der Klappe führt." Bei Kindern sei diese Reaktion besonders heftig, weshalb die herkömmlichen biologischen Klappen nur wenige Jahre hielten.
Faserbildung wie bei Zuckerwatte
27.612 Mal haben Ärzte im vergangenen Jahr in deutschen Kliniken Herzklappen durch Prothesen ersetzt, wie aus Daten des Statistischen Bundesamts hervorgeht. In 61 Fällen davon waren die Patienten nicht älter als 20, viermal sogar jünger als ein Jahr. Zum Vergleich: 78 Herzklappenprothesen mussten bei Patienten bis 20 Jahre ausgetauscht werden. Insgesamt verzeichneten die Statistiker nur 1852 Wechsel.
"Wir suchen einen zellfreien Ersatz", sagt Schenke-Layland, die auch Professorin an der Universitäts-Frauenklinik Tübingen ist. Mit ihrem Team hat sie ein Trägersubstrat entwickelt, das aus einer Kombination natürlicher und synthetischer Polymere elektrisch gesponnen wird. Ähnlich wie bei Zuckerwatte werden Fasern gebildet und vernetzt. Darin eingewebt werden Proteine, die - so die Idee - nach dem Einpflanzen in den Menschen Zellen aus der Umgebung anziehen. Daraus soll sich eine neue Herzklappe entwickeln. Das erzeugte Grundgerüst - eben das weiße, dünne Plättchen - soll sich später selbst auflösen. "Das Kritische ist: Wann weiß die Klappe, dass sie aufhören muss, zu wachsen?", sagt Schenke-Layland.
Versuchsreihe wird an Schweinen gestartet
In der Petrischale, im Fachjargon "in vitro" genannt, seien schon Erfolge zu verzeichnen. Eingebaut in Schweineherzen von toten Tieren halten die Ersatzklappen der Stuttgarter auch Tests stand. In einem Bioreaktor, der Wasser durch die Klappen pumpt wie das Herz Blut, ist kaum ein Unterschied zwischen der künstlichen und den echten Klappen zu erkennen - nur dass die eingesetzte etwas verzögert reagiert.
Nun soll es bald "in vivo", also ins Lebewesen gehen. Gemeinsam mit einer amerikanischen Universität werde eine Versuchsreihe an Schweinen gestartet, sagt Schenke-Layland. "Nach etwa einem halben Jahr können wir dann absehen, ob es generell klappen kann."
2,7 Millionen Euro investiert die Fraunhofer-Gesellschaft über fünf Jahre in das Projekt. "Obwohl das Ziel ein Produkt ist, geht es erst mal um Grundlagenforschung", erklärt Schenke-Layland. Da es aber schon praktikable - wenn auch mitunter problematische - Lösungen für defekte Herzklappen gibt, drehen ihren Angaben zufolge viele Geldgeber den Hahn zu. Nur noch wenige Gruppen weltweit forschten trotzdem weiter für den idealen Ersatz.
Ansprüche sind hoch
Die Hannoveraner um Haverich wählen einen anderen Weg: Sie waschen aus menschlichen Klappen alle fremden Zellen. Schon über 120 der so entstehenden dezellularisierten Kollagen- und Elastingerüste seien erfolgreich implantiert worden, sagt Horke. Allerdings komme es eben auf die passende Größe an. "Wenn wir eine Lösung finden, bei der jede Größe hergestellt werden kann, wäre das natürlich wunderbar."
Da die heute verfügbaren Präparate bereits 10 bis 20 Jahre halten, sind die Anforderungen an neue Entwicklungen und die Barrieren, um auf den Markt zu kommen, aus Sicht von DZHK-Vorstand Eschenhagen hoch. "Die müssen vor allem zeigen, dass sie länger und besser instand bleiben." Das wiederum lasse sich im Grunde aber auch erst nach eben jenen 10 bis 20 Jahren beurteilen.
Aus der Entwicklung am IGB sollen irgendwann einmal schnell einsetzbare Klappengrundgerüste werden. Wie lange das dauern wird, vermag Schenke-Layland noch nicht zu sagen. Da die Stuttgarter aber ohne Zellen im Trägersubstrat arbeiten, könnte die Zulassung als Medizinprodukt schneller als bei anderen Ansätzen laufen.
Quelle: ntv.de, Marco Krefting, dpa